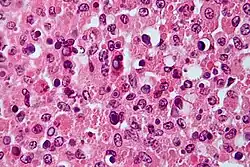

Michaelis–Gutmann bodies
Michaelis–Gutmann bodies (M-G bodies) are concentrically layered basophilic inclusions found in Hansemann cells in the urinary tract. These are 2 to 10 μm in diameter, and are thought to represent remnants of phagosomes mineralized by iron and calcium deposits.
M-G bodies are a pathognomonic feature of malakoplakia, an inflammatory condition that affects the genitourinary tract. They were initially discovered in 1902 by Leonor Michaelis and Carl Gutmann.
Michaelis-Gutmann bodies stain positive for von kossa (calcium), Prussian Blue (iron), and PAS diastase stain.